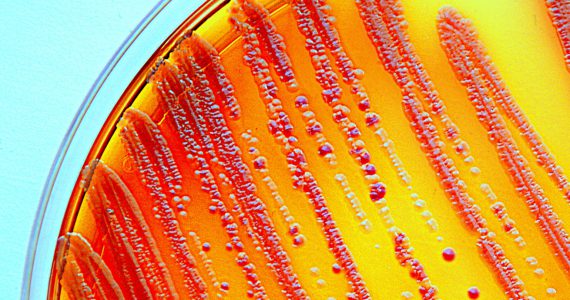

At the pace we’re going, it could take more than two centuries to achieve gender equity. But more women in leadership and changing cultural attitudes could speed things up for the engineering industry.
The World Economic Forum’s (WEF) latest Global Gender Gap Report, published late last year, stated that it will take 217 years for there to be gender equity across the 144 countries surveyed.
This is up from the 170 years estimated in 2016, making this the first backwards slide since 2004. Clearly, something needs to change.
The OECD also reported last year that although Australian women are now more likely to gain a university degree than their male peers, only 37 per cent of STEM graduates are women.
Engineers Australia (EA) National President and Board Chairman, the Hon Trish White, said there is a stark disparity between the number of women and men in the engineering profession, with women representing just under 12 per cent of the profession.
Slow progress
White said these figures are unlikely to improve quickly, and the biggest culprits are low rates of engagement and retention of women and girls.
“Only 6 per cent of girls study maths and physics at school, and half of the women who graduate leave the engineering profession,” she said.
According to statistics released this month by the Workplace Gender Equality Agency (WGEA), pay gaps for some major engineering sectors are also higher than the national average of 15.3 per cent. In construction, and professional and technical services, the gap is 20.2 and 22.6 percent, respectively, although manufacturing is better than average with a 12.8 per cent disparity.
While White admitted it’s easy to be disheartened by the slow progress towards gender equity in engineering, she believes a more deliberate approach to resolving these issues could reap dividends.
Visible change
According to White, increasing the number of visible female role models for women is essential to making progress towards gender equity in engineering.
“It’s hard to be what you cannot see,” she explained.
A recent WEF analysis found the percentage of female leaders in manufacturing, mining and energy is less than 10 per cent. It also revealed that industry sectors with more female leaders hired more women as employees.
White said EA is tackling the challenge of increasing the number of visible role models on a range of fronts, including setting a target of 30 per cent female leadership within the organisation by 2020.
“We’ve set a commitment across the organisation to walk the talk,” White said.
Other EA initiatives include working with leaders across industries to help Australian employers and organisations work out how best to achieve better representation, and ensuring that there are women alongside men on every speaking panel and committee.
According to White, some progress has already been made on these fronts. She heads up the EA National Board, which boasts two other prominent women engineers as directors.
“Half of our highest [governing] body is women,” White said.
Cultural attitudes and critical mass
However, these efforts to close the widening gender gap across engineering will hit a wall unless cultural attitudes in the community and industry change.
“I think that people are becoming more bold and vocal in their discrimination. Social media – together with the anonymity of electronic communication – is contributing,” White said.
A “critical mass” of women in the workforce is needed before the momentum for more rapid change can be reached, she said.
As examples of progress, White praised the engineering employers who are participating in the Male Champions of Change program, which encourages male leaders to advocate for and promote gender equity within their organisations.
Another is a pilot initiative that offers school-term contracts for parents of school-aged children.
The director of the WGEA, Libby Lyons, agreed that leadership and accountability in the workforce are essential to shift entrenched inequality.
“It is only through more employers showing this type of leadership and accountability that we will see the pace of real change increase,” she said.
Several notable engineering employers including AECOM, Arcadis, GHD and Aurecon have recently received citations from the WGEA as employers of choice for gender equality.
The transport, mining, construction, and electricity, gas, water and waste services industries were not well represented on the list, with only one company in each category receiving the WGEA’s stamp of approval.
Inspiration and support
The WEF figures have certainly reverberated around the industry, and the backwards slide inspired this year’s International Women’s Day theme of Press for Progress.
White admires the confidence of young women in engineering and encourages them to support each other and be true to their own vision of themselves as professionals.
“I spent a lot of my career trying to fit in, pretending that discrimination and put downs didn’t matter,” she said.
She forgives herself for adapting to survive, but stresses that current legal protections mean that women should no longer have to put up with workplace discrimination.
White will offer more inspiration and insights during her appearances at EA’s International Women’s day events on 7, 8, and 9 March, alongside Shark Tank’s Naomi Simson.